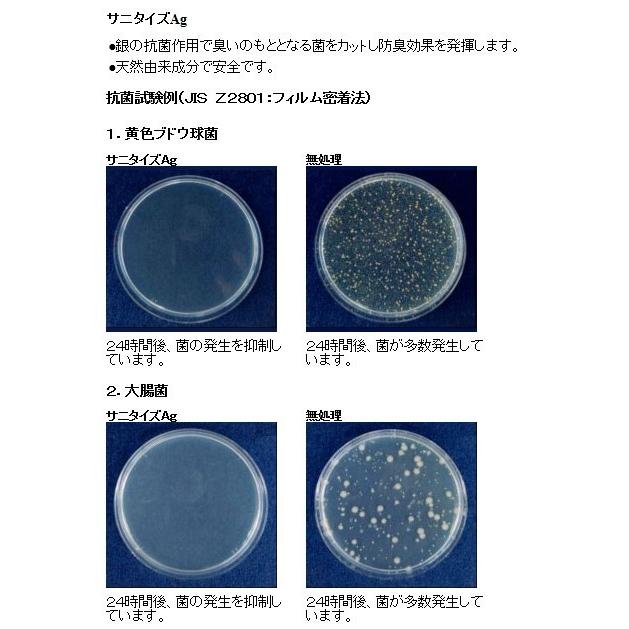

楽天市場

楽天市場 ビニールバレー ボールの通販
yahoo ショッピング yahoo japan

youtube

ビニールバレーボール大会 醍醐 天ぷらへの道

fenestra spb ru

仙南地区福祉施設親善スポーツビニールバレー大会参加報告 医療法人金上仁友会 金上病院

ptaビニールバレーボール大会 横手市立 横手南小学校

ビニールバレーボール大会 鬼首地区公民館ブログ

楽天市場 ビニール バレー 宮城県の通販

上履き ビニール製 幼稚園 小学校 ムーンスター ビニールバレー 上靴 シロ シロ buyee buyee japanese proxy service buy from japan bot online

https encrypted tbn0 gstatic com images q tbn and9gcqbhayfklf0qqai8gxzncgukphxtwq6sjttpqtkas44pvw0z gu usqp cau

ブルー日記

amazon アキレス 上履き バレー 日本製 ビニール製 14cm 28cm 2e キッズ 男の子 女の子 vhb 4200 スクール 上履き

ビニールバレー シロ ホワイト 公式 moonstar online store

markazvaka net

サトー園芸店 花キューピットタウン

ムーンスター ビニールバレー 白 ホワイト 22 0cm 上履き 体育館履き 上靴 小学校 中学 高校 介護 リハビリ 屋内 子供 大人 男女 靴 日本製 product details yahoo auctions japan proxy bidding and shopping service from

楽天市場 上履き 子供 ムーンスター ビニールバレー バレーシューズ ビニール 14cm 25cm 内ズック 内履き 上靴 学校 小学校 幼稚園 保育園 スクール キッズ ジュニア 月星 取寄せ すててこねっと

第9回山形県ビニールバレー愛好会大会開催 山形県理容生活衛生同業組合

ビニールバレー大会 instagram posts photos and videos picuki com

agrowecuador com

上履き 子供 ムーンスター ビニールバレー バレーシューズ ビニール 14cm 25cm 取寄せ au pay マーケット

ムーンスター 上履きビニールバレー 白 赤 au pay マーケット

moonstar ムーンスター ビニールシューズ バレーシューズ ビニールバレー 上履き 上靴 23 5cm の落札情報詳細 ヤフオク落札価格情報 オークフリー スマートフォン版

amazon ミカサ mikasa ソフトバレーボール 教材用 ビニールタイプ 100g soft100g ミカサ スポーツ アウトドア

大雪吹き飛ばせ ビニールバレーボール大会

プリンスの短刀直毛 んだ ブログ

ビニールバレーシューズ 25センチ フリマアプリ ラクマ

ビニールバレーボール はぐみんかえで
You May Like























































































